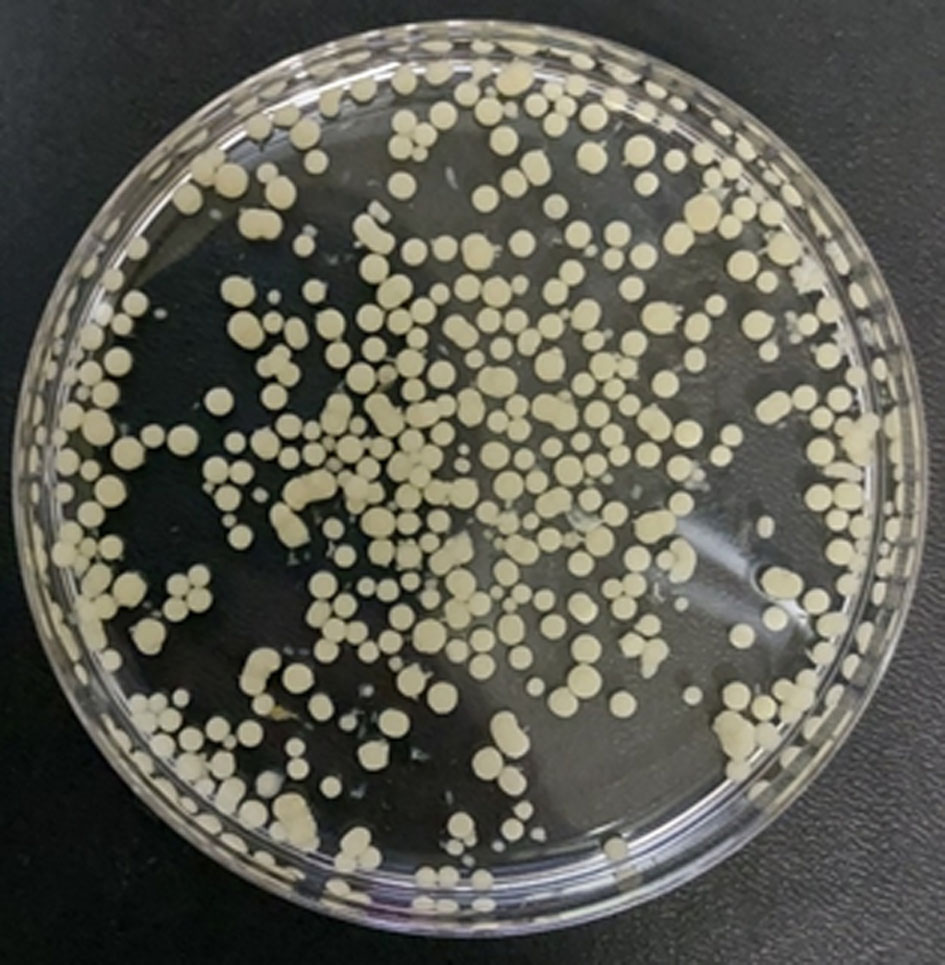
Фото грибных пеллет гриба белой гнили Trametes hirsuta

БИОДЕГРАДАЦИЯ ХЛОРАЦЕТАМИДНОГО ГЕРБИЦИДА БУТАХЛОРА ГРИБОМ БЕЛОЙ ГНИЛИ TRAMETES HIRSUTA LE-BIN 072
БИОДЕГРАДАЦИЯ ХЛОРАЦЕТАМИДНОГО ГЕРБИЦИДА БУТАХЛОРА ГРИБОМ БЕЛОЙ ГНИЛИ TRAMETES HIRSUTA LE-BIN 072
Аннотация
Бутахлор — хлорацетамидный довсходовый гербицид с периодом полураспада до 29 дней, сохраняется в окружающей среде, оказывая токсическое воздействие на живые организмы. В рамках исследования была проведена оценка способности гриба белой гнили Trametes hirsuta к биодеструкции бутахлора. Показано, что на 10 сутки инкубирования грибных пеллет остаточное содержание гербицида в культуральной среде составляло менее 5% от исходного содержания (200 мг/л). Анализ активностей лигнолитических ферментов показал, что внесение бутахлора в среду культивирования индуцировало секрецию грибом как лакказ, так и различных грибных пероксидаз II класса — Mn-зависимых пероксидаз (MnP) и Mn-независимых пероксидаз (лигнин пероксидазы LiP, универсальной пероксидазы VP). Индукция лигнолитических пероксидаз была выше, чем лакказ — активность возрастала в 9 и 15 раз, достигая значений 400 и 35 Ед/мл для Mn-зависимых и Mn-независимых пероксидаз соответственно. При этом максимальная активность лакказ (120 Ед/мл) детектировалась на 3-и сутки инкубирования, тогда как максимальная активность пероксидаз наблюдалась на 5–7-й день. В конце культивирования грибных пеллет с гербицидом (15 сутки) по данным ИФА в культуральной среде обнаруживался конкурентный метаболит. Продукты деструкции бутахлора по данным in vitro тестирования с использованием коммерческого набора XenoScreen XL YES Assay kit эстрогенной активностью не обладали.
1. Введение
Широкое использование пестицидов в современном сельском хозяйстве не только обеспечило высокую и стабильную урожайность агрокультур, но и привело к попаданию в окружающую среду множества токсичных веществ, загрязняя почву, воду и сельскохозяйственную продукцию. Гербициды являются одним из наиболее широко используемых типов пестицидов, на долю которых приходится около 50% международного рынка пестицидов и которые используются для избирательного уничтожения или подавления роста растений.
Гербициды из химического класса хлорацетанилидов (или хлорацетамидов) (рис. 1) благодаря широкому спектру гербицидных свойств и низкой стоимости, широко применяются для борьбы с однолетними злаковыми и некоторыми двудольными сорняками в посевах многих культур, таких как рапс, подсолнечник, соя, кукуруза и свекла
, . Они вносятся на почву до всходов культуры (с заделкой или без), защищая посевы от сорняков в течение длительного времени. Это обеспечивает эффективную борьбу с сорной растительностью на ранних стадиях роста культурных растений. Эти селективные и системные гербициды подавляют синтез длинноцепочечных жирных кислот, предотвращая нормальный рост проростков сорняков .Ацетохлор и бутахлор являются также очень популярными гербицидами в Азии с нормой расхода около 4,5 × 107 кг в год
, при рекомендуемой дозировке 3000 мл га−1 . На Индию приходится около 6,75 × 106 кг годового использования бутахлора . S-метолахлор применяется в России как селективный довсходовый почвенный гербицид для борьбы с однолетними злаковыми и некоторыми двудольными сорняками на посевах таких культур, как кукуруза, подсолнечник, соя, сахарная свекла, рапс и капуста . В сельском хозяйстве США в 2021 г. было использовано 41,7 млн фунтов ацетохлора согласно данным Министерства сельского хозяйства США (USDA) .
Рисунок 1 - Гербициды из химического класса хлорацетамидов
В связи с вызываемыми неблагоприятными эффектами на окружающую среду и здоровье человека удаление хлорацетамидов из почвы и воды стало ключевым направлением современных исследований. Хотя для обработки пестицидов доступны различные химические и физические процессы, такие как фотоокисление, химический гидролиз и адсорбция, более эффективным подходом являются недорогие и экологически безопасные технологии биоремедиации , . Использование биологических методов удаления пестицидов способствуют также восстановлению качества почвы и повышают ее плодородие .
Биоремедиация, опосредованная грибами, или микоремедиация, является инновационной многообещающей технологией очистки окружающей среды от экотоксикантов, благодаря своей экономической эффективности, экологичности и универсальности . В последние годы детоксикация загрязненных земельных и водных ландшафтов путем применения одного или нескольких видов грибов в качестве природных агентов привлекает внимание ученых как эффективный инструмент для восстановления окружающей среды. По сравнению с другими микроорганизмами, грибы могут не только быстро поглощать ксенобиотики и выживать в условиях с недостаточным содержанием питательных веществ, кислых значениях pH, низком содержании воды, но и продуцировать различные внеклеточные ферменты, которые могут взаимодействовать с различными поллютантами с высокой степенью неспецифичности. Таким образом, разнообразие грибов и их способность вырабатывать широкий спектр специфических и неспецифических ферментов делают грибы идеальными кандидатами для борьбы с широким спектром загрязняющих веществ. Они могут быть эффективны в очистке in situ или ex situ от различных загрязняющих веществ, таких как тяжёлые металлы, красители, гербициды и фармацевтические препараты , , , .
В данной работе была проведена оценка способности гриба белой гнили Trametes hirsuta к биодеструкции хлорацетамидных гербицидов на примере бутахлора.
2. Методы и принципы исследования
Пеллеты гриба белой гнили Trametes hirsuta LE-BIN 072 из Коллекции культур базидиомицетов LE-BIN Ботанического института им. В.Л. Комарова Российской академии наук (Санкт-Петербург, Россия) культивировали на минеральной среде следующего состава (г/л): KH2PO4 — 0.6; K2HPO4 — 0.4; MgSO4•7H2O — 0.5; CaCl2 — 0.05; MnSO4 — 0.05; ZnSO4 — 0.001; FeSO4 — 0.0005; NaNO3 — 3.0; глюкоза — 10.0. Перед внесением грибных пеллет (из расчета 10 г сырой биомассы на 100 мл ростовой среды) в опытные колбы добавляли бутахлор в концентрации 200 мг/л, инкубировали в течение 15 суток на роторной качалке при 100 об./мин и 25°C. В ходе инкубации проводился отбор проб культуральной среды, в которых определяли остаточное содержание бутахлора и активность лигнолитических ферментов.
Определение остаточного содержания бутахлора (N-(бутоксиметил)-2-хлор-N-(2,6-диэтилфенил)ацетамид) в ростовой среде в процессе инкубации грибных пеллет (рис. 2) проводили методом ВЭЖХ и конкурентного ИФА, для чего готовили экстракты образцов культуральной жидкости на разных стадиях культивирования гриба и деградации бутахлора в дихлорметане (ДХМ) — 1:1 (об./об.). Затем экстракты упаривали, осадок перерастворяли в эквивалентном объеме 10 мМ ФБС с 20% метанола, далее растворы либо разбавляли 10 мМ ФБС с 20% метанола в 10 раз, либо использовали неразбавленными. ИФА проводился по методике с модификациями.
Для проведения ИФА конъюгат БСА и производным бутахлора с концентрацией 1.0 мкг/мл в 10 мМ ФБС сорбировали в лунки микропланшета в течение ночи при 4°C. Затем микропланшет три раза промывали ФБС, содержащим 0.05% Твин-20 (ФБСТ). После стадии иммобилизации и промывки микропланшета в лунки вносили 50 мкл растворов бутахлора в соответствующей среде — либо 10 мМ ФБС с 20% метанола (концентрации в диапазоне 20000–0.12 и 0 нг/мл), либо восстановленной в том же буфере пробы, а также 50 мкл антисыворотки (разведение 1:9000). Концентрации и разведения конечные в лунках. Затем микропланшет инкубировали в течение 1 ч при 37°С. После отмывки ФБСТ добавляли антивидовые антитела, конъюгированные с пероксидазой хрена (разведение препарата 1:3000). После промывки (три раза ФБСТ и один раз дистиллированной водой) определяли активность ферментной метки, связавшейся с носителем, добавляя 100 мкл раствора субстрата (коммерческий раствор ТМБ+H2O2) и останавливая реакцию через 15 мин добавлением 50 мкл 0.1 М H2SO4. Оптическую плотность измеряли при 450 нм и строили график зависимости оптической плотности от концентрации бутахлора с использованием программного обеспечения Origin 9.0 (OriginLab, США).
Рисунок 2 - Фото грибных пеллет гриба белой гнили Trametes hirsuta
Анализ эстрогенной активности метаболитов бутахлора in vitro проводили с использованием коммерческого набора XenoScreen XL YES Assay kit (Xenometrix, Швейцария) в соответствии с инструкциями производителя. В тесте YES используется рекомбинантный штамм дрожжей Saccharomyces cerevisiae, содержащий плазмиду с рецептором человеческого эстрогена hERα, связанным с геном lacZ, который кодирует β-галактозидазу . Затем реакция на химическое вещество или смесь измеряется с помощью субстрата для β-галактозидазы, продукт которой приводит к цветному или флуоресцентному сигналу. Взаимодействие рецептора hERα с молекулой лиганда модулирует транскрипцию репортерного гена lacZ и продукцию β-галактозидазы, которая, взаимодействуя с субстратом (хлорфенол красный-β-D-галактопиранозид, CPRG) приводит к образованию окрашенных продуктов. Измеряемая оптическая плотность при длине волны 570 нм напрямую коррелирует с количеством секретируемой β-галактозидазы и, следовательно, с активностью тестируемого вещества, связывающегося с рецептором эстрогена hERα.
Все эксперименты проводились в 3-х биологических повторах и с использованием соответствующих градуировочных кривых.
3. Основные результаты
Была изучена способность дереворазрушающего гриба белой гнили Trametes hirsuta LE-BIN 072 к биодеструкции гербицида бутахлора. Рекомендуемая полевая доза внесения хлорацетамидных гербицидов составляет 5–10 мг/кг , . В соответствии с литературными данными , , в предварительном эксперименте по влиянию гербицида на рост грибной биомассы были взяты следующие концентрации бутахлора — 10 мг/л (1×), 50 (5×), 100 (10×) и 200 (20×) мг/л. Результаты эксперимента показали, что даже при 20-ти кратном увеличении рекомендуемой дозы рост гриба не ингибировался. Количество сырой биомассой в конце инкубации (15 суток) было сопоставимо с таковой при культивировании грибных пеллет на контрольной среде без гербицида и составляло около 100 г/л сырой биомассы. Действительно, в условиях полевых экспериментов было продемонстрировано, что при внесении в почву 10-и кратных норм применения различных пестицидов (как в смеси, так и по отдельности), численность представителей отдела Basidiomycota в грибных сообществах увеличивалась, то есть ингибирующий эффект на рост базидиомицетов отсутствовал . В дальнейших экспериментах по изучению биодеструкции гербицида грибом T. hirsuta концентрация бутахлора в ростовой среде составляла 200 мг/л.
В процессе инкубирования грибных пеллет отбирали образцы культуральной жидкости (КЖ) и определяли в них концентрацию бутахлора с использованием двух независимых аналитических методов — ВЭЖХ и ИФА (рис. 3 и 4).

Рисунок 3 - Динамика убыли содержания бутахлора в образцах культуральных жидкостей, отобранных в разные дни инкубирования пеллет Trametes hirsuta. Концентрация бутахлора определена методом ВЭЖХ

Рисунок 4 - Гистограмма, демонстрирующие убыль бутахлора в образцах культуральных жидкостей (черные столбцы) и возрастание количества конкурирующего в ИФА продукта деградации бутахлора (красные столбцы)

Рисунок 5 - Корреляционная кривая, полученная по результатам тестирования проб, полученных методами ВЭЖХ и ИФА
Динамика изменения активностей лигнолитических ферментов в процессе инкубирования грибных пеллет на контрольной минеральной среде и на этой же среде с внесением бутахлора представлена на рисунке 6. Показано, что внесение бутахлора в среду культивирования сильно индуцировало секрецию как лакказ, так и грибных пероксидаз — Mn-зависимых пероксидаз (MnP) и Mn-независимых пероксидаз. По сравнению с лакказами, индукция лигнолитических пероксидаз была выше — активность возрастала в 9 и 15 раз для MnP и Mn-независимых пероксидаз соответственно. При этом максимальная активность лакказы детектировалась на 3-й сутки культивирования, тогда как максимальная активность пероксидаз наблюдалась на 5–7-й день.

Рисунок 6 - Динамика ферментативных активностей в культуральной среде гриба Trametes hirsuta:
а – лакказная активность (субстрат АБТС); б – активность Mn-зависимых пероксидаз (субстрат Mn2+); в – активность Mn-независимых пероксидаз (субстрат вератровый спирт)
4. Обсуждение
С использованием 2-х аналитических методов ВЭЖХ и конкурентного ИФА показано, что содержание бутахлора в культуральной среде снижается более эффективно в первые 2 дня инкубирования грибных пеллет T. hirsuta (рис. 3 и 4), что может быть связано с эффективной сорбцией бутахлора на грибном мицелии в первые сутки культивирования. Последующее более медленное снижение содержания бутахлора в образцах КЖ может быть опосредовано секрецией грибом лигнолитических ферментов (рис. 6), участвующих в биодеградации гербицида. Так, на 3-и сутки инкубирования отмечено значительное возрастание активности лакказы на среде с бутахлором (рис. 6а). Недавно было высказано предположение, что лакказа может играть значительную роль в деградации как бутахлора, так и других хлорацетамидных гербицидов . Дальнейшее инкубирование грибных пеллет в присутствии гербицида приводило к значительной индукции пероксидазной активности (рис. 6б и 6в). Аналогичная динамика ферментативных активностей T. hirsuta была продемонстрирована при биодеградации грибом соединения эфира фталевой кислоты DiBP . При этом анализ секретомов гриба T. hirsuta показал увеличение продукции основных ферментов лигнолитического комплекса гриба, таких как лакказы и грибные пероксидазы II класса, в том числе MnP, LiP и VP . Хорошо известно, что ферменты лигнолитического комплекса грибов участвуют в деструкции различных ксенобиотиков, как-то полиароматические углеводороды ПАУ, различные красители и антибиотики, эфиры фталевой кислоты и ряд других . Ранее было показано, что лигнолитические ферменты гриба T. hirsuta участвуют в биодеградации красителя RBBR , эфиров фталевой кислоты , .
В конце инкубирования (на 15 сутки) наблюдался эффект, при котором по результатам ВЭЖХ анализа бутахлор в КЖ содержался в следовых количествах (рис. 3), однако по данным ИФА наблюдалась выраженная конкуренция за связывание антител (рис. 4). Вероятно, в результате деградации бутахлора грибом T. hirsuta в культуральной среде образуется конкурирующий метаболит, распознаваемый антителами. До недавнего времени было известно только о трёх штаммах почвенных грибов (Fusarium solani и F oxysporum, Chaetomium globosum) способных разлагать бутахлор . Процессы разложения бутахлора почвенными грибами в основном включают дехлорирование, гидроксилирование, дегидрирование, дебутоксиметилирование, деалкилирование и циклизацию. Среди образующихся метаболитов были обнаружены 2-хлор-N-(2,6-диэтилфенил)-N-метилацетами; 2-хлор-N-(2,6-диэтилфенил)ацетамид; N-(2,6-диэтилфенил)ацетамид; 2,6-диэтиланилин и др.
Тестирование in vitro показало отсутствие эстрогенной активности в образцах КЖ после биодеструкции. Необходимо проведение дальнейшего более детального изучения механизма биодеструкции хлорацетамидных гербицидов грибом белой гнили T. hirsuta.
5. Заключение
Доказано, что микроорганизмы и их ферменты эффективны в биодеградации хлорацетамидных гербицидов, включая бутахлор. В некоторых исследованиях изучались пути микробной деградации бутахлора, но механизмы его деградации всё ещё требуют дальнейшего систематического изучения, в особенности, что касается грибных генов и ферментов, связанных с деградацией данного гербицида. В настоящем исследовании показано, что дереворазрушающий гриб белой гнили Trametes hirsuta способен эффективно разрушать бутахлор. В процессе биодеструкции задействован комплекс лигнолитических ферментов гриба, таких как лакказы и пероксидазы. Образующиеся при этом метаболиты бутахлора не обладают эстрогенной активностью.
